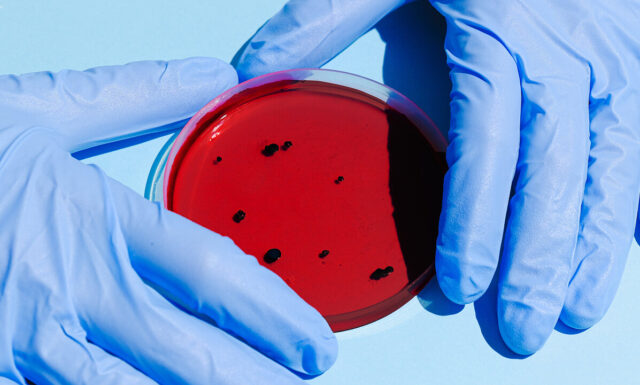

Житомирський лабораторний центр збільшив кількість тестувань до 1000 на добу. Це зумовлене не тільки зростанням кількості хворих, а й оновленням обладнання центру.
"16.10.2020 року лабораторним центром отримано автоматичну станцію для пробопідготовки (для екстракції нуклеїнових кислот), вартістю 950 000 грн. В присутності представника постачальникастанція пройшла випробування та проведено навчання працівників лабораторного центру. 17.10.2020р. були тренувальні заняття для лаборантів – бактеріологів, під час яких фахівці здобули практичні навички щодо роботи з даною апаратурою", – повідомили у лабораторному центрі.
За минулі дві доби кількість тестувань становила 700-1000.
Як зазначили в обласному лабораторному центрі, невдовзі планують відкрити вірусологічний підрозділ у Новоград-Волинському. Вже закупили необхідне обладнання та устаткування.
Нагадаємо, за минулу добу 18 жовтня в Житомирщині зареєстрували новий антирекорд.